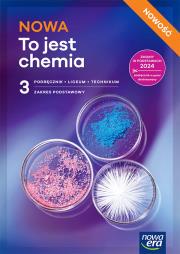
Okładka książki Nowa chemia podręcznik 3 liceum i technikum zakres podstawowy edycja 2026

Nowa chemia podręcznik 3 liceum i technikum zakres podstawowy edycja 2026
Wydawca:
Nowa Era
wysyłka: 48h
ISBN:
9788326753329
EAN:
9788326753329
Oprawa:
Miękka
Format:
240x170x11mm
Liczba stron:
230
Rok wydania:
2026
(0) Sprawdź recenzje
17% rabatu
52,12 zł
Cena detaliczna:
62,50 zł
DODAJ
DO KOSZYKA
dodaj do schowka
koszty dostawy
Najniższa cena z ostatnich 30 dni: 50,85 zł
Opis produktuZasady bezpieczeństwaCzym różni się podręcznik NOWOŚĆ z 2026 r. od podręcznika z ubiegłych lat? Podręcznik NOWOŚĆ jest dostosowany do podstawy programowej z 2024 roku zawiera treści, które aktualnie obowiązują. Podręcznik jest częścią trzecią serii podręczników do zakresu podstawowego. W podręczniku NOWA To jest chemia szczególny nacisk położono na dostosowanie treści do możliwości uczniów. Nowy podręcznik ze zbiorem zadań uwzględnia też aktualny stan wiedzy chemicznej oraz aktualne dane zgodne z tablicami chemicznymi CKE. Przypomnienia najważniejszych wiadomości, ze szkoły podstawowej oraz części 1. i 2. podręcznika, ułatwiają naukę. Wyróżnione zagadnienia Ważne w temacie pomagają znaleźć kluczowe treści. Dokładnie opisane doświadczenia chemiczne uczą opisywania obserwacji i formułowania wniosków. Przykłady z Planem rozwiązywania tłumaczą krok po kroku, jak rozwiązywać zadania problemowe i obliczeniowe. Infografiki dobrze wyjaśniają teorię i procesy chemiczne. Podsumowania i Sprawdź, czy potrafisz wspierają przygotowania do sprawdzianów. Zbiór zadań zawiera 161 zadań i zapewnia systematyczne ćwiczenie kluczowych umiejętności. x


Uwaga!!!
Ten produkt jest zapowiedzią. Realizacja Twojego zamówienia ulegnie przez to wydłużeniu do czasu premiery tej pozycji. Czy chcesz dodać ten produkt do koszyka?
TAK
NIE

Wybierz wariant produktu
|








